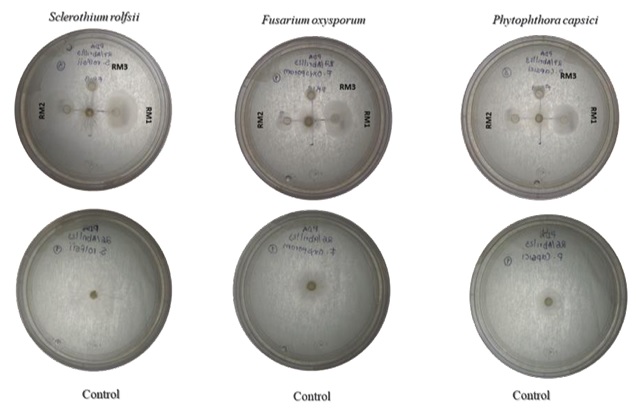

Introducción
El maíz, por su importancia cultural, social y económica es considerado la base en la dieta de los mexicanos (SADER, 2020). La Organización de las Naciones Unidas para la Agricultura y la Alimentación, coloca al maíz como el segundo cereal más producido en el mundo, México cuenta con 64 variedades de maíz, de las cuales 59 son catalogadas nativas (maíces criollos). El estado de Sinaloa, México es líder en la producción de maíz blanco representando el 75% de lo producido en todo el país (SADER, 2020).
La producción de maíz en el estado de Sinaloa enfrenta principalmente problemas fitosanitarios que provocan altas pérdidas en rendimiento desde el establecimiento del cultivo hasta el almacenamiento del grano; aunado a los altos costos de producción, resultando cada día menos sostenible el modelo de producción convencional donde el uso indiscriminado de agroquímicos y actualmente la escases de agua para riego ha generado desgaste y disminución de la producción. Actualmente el uso de bioinsumos a base de microorganismos ha adquirido gran importancia para el sector agrícola; restableciendo la interacción planta-microrganismo. Diversos estudios reportan beneficios que los microorganismos endófitos inducen en las plantas por diferentes mecanismos como: respuesta de adaptación al estrés ambiental, antagonismo contra fitopatógenos y promoción del crecimiento vegetal (Ruiz-Sánchez, Mejía, Cristóbal, Valencia y Reyes, 2014; Orberá, Serrat y Ortega, 2014; Liu, Zuo, Zou, Wang y Song, 2013). Las bacterias endófitas comprenden un grupo heterogéneo asociadas a diversas partes de la planta, sin embargo la relación planta hospedante y comunidad bacteriana endófita, refleja un proceso de colonización influenciado por diversos factores como: genotipo, edad fenológica de la planta, estado fisiológico y tejido, otras variables importantes como tipo de suelo, temperatura, humedad y prácticas agronómicas (Gupta, Parihar, Ahirwar, Senehi y Singh, 2015). Diversos estudios han reportado en diferentes genotipos de maíz, así como en Teozintle (ancestro del maíz), que la inducción de germinación y rendimiento se relaciona directamente con la inoculación de bacterias endófitas de diversas especies de Bacillus (Sánchez-Bautista, De León, Aranda, Zavaleta, Nava, Goodwin, Leyva, 2018). Actualmente en la comunidad científica se ha despertado interés por conocer los microecosistemas endófitos-planta, todavía hay varias preguntas sobre cómo y por qué los endófitos se desarrollan, mantienen el equilibrio y cómo favorecen los procesos de crecimiento en las plantas. Es importante la realización de investigación continua en la agricultura, ampliando el entendimiento de los mecanismos de la interacción bacteria endófita-planta, así como la influencia de dichos microrganismos en la salud del suelo y productividad agrícola (Gonzales-Torrico, Cortes, Blanco y Loayza, 2024; Li, Xiong, Wen, Li y Xu 2023). Actualmente se trabaja en la aplicación de innovadoras estrategias en la búsqueda de la sostenibilidad agrícola; destacando las características de biocontrol de los microorganismos endófitos en enfermedades fúngicas agrícolas, así como la promoción del buen desarrollo de las plantas (Montañez-De Azcué, Cristóbal, Uc, Moo y Tun, 2024).
Por lo que el objetivo de esta investigación fue aislar y caracterizar molecularmente bacterias endófitas aisladas de plantas de maíz (Zea mays L.), así como evaluar in vitro la capacidad de promoción de crecimiento vegetal (BPCV) y actividad antagónica frente a hongos fitopatógenos (Sclerotium rolfsii y Colletotrichum coccodes) y Oomycete Phytophthora capsici como una alternativa sustentable en la producción del cultivo de maíz en el estado de Sinaloa, México.
Materiales y Métodos
Obtención de material vegetal y esterilización
Se recolectaron plantas de maíz blanco híbrido PIONEER 4032 DEKALB, variedad sembrada durante el ciclo otoño-invierno 2022-2023 en terrenos del campo cuatro caminos, con tipo de suelo franco arcilloso, localizado en el municipio de Guasave, Sinaloa; México, 25.5675° N y 108.4676° O. El muestreo de las plantas se realizó en la fase reproductiva (visualizando la espiga), al azar y en forma de zig-zag, considerando plantas sin signos de enfermedad o daño. Se recolectó tejido foliar considerando la parte central de cada planta; de la parte alta se tomó de tallo, la muestra de raíz se tomó aproximadamente a seis centímetros de profundidad. Las muestras de tejido se tomaron utilizando material estéril (guantes, tijeras pinzas), en cada toma de muestra el material se esterilizaba con etanol al 96%. Cada muestra se rotuló, con fecha de muestreo y se colocaron en bolsas de plástico estériles, conservándose en hieleras a 4 oC para su procesamiento dentro de las 24 h de su colecta en el Laboratorio de Ciencias Básicas de la Universidad Autónoma de Occidente, Unidad Regional Guasave, Sinaloa, México. El tejido vegetal recolectado en campo (foliar, tallo y raíz), fue separado, para su lavado, se descartaron impurezas de manera cuidadosa con agua de grifo durante cinco minutos, posteriormente se agregaron tres gotas de detergente líquido y se realizaron tres lavados más de manera similar. El tejido vegetal se desinfectó por un minuto, en solución de etanol al 70% (Sigma-Aldrich), posteriormente se realizaron lavados en solución de hipoclorito de sodio al 1% durante 10 min adicionando Tween-80 al 10% (v/v) por un minuto, para finalizar, se realizaron seis lavados con agua destilada estéril.
Aislamiento de bacterias
Se realizó el aislado de bacterias aplicando la técnica denominada contacto directo en condiciones asépticas realizando pequeños cortes transversales y longitudinales al tejido, colocándolos en cajas Petri preparadas con medio agar Lb (Schaad, Jones y Chun, 2001); el establecimiento se realizó por triplicado en cada tejido, posicionado el corte de cara al medio de cultivo, para posteriormente incubarlos durante ocho días a 27 °C (Yang et al., 2011). Como control de esterilización se tomaron 100 µL de agua destilada del último lavado estableciéndose bajo las mismas condiciones del tejido. Pasado el tiempo se realizaron seis rondas de purificación hasta obtener colonias con características morfológicas similares; la realización del análisis morfológico se realizó en estereoscopio después de 48 h de crecimiento; considerando: forma, bordes, aspecto, color, tamaño.
La densidad poblacional de bacterias aisladas de las muestras de tejido (foliar, tallo y raíz), se realizó por conteo directo en placa utilizando contador de colonias (Quebec®, Darkfield Colony Counter). Expresando en unidades formadoras de colonias por gramo de peso fresco (UFC g-1), transformándose a Log10 UFC g-1. Se realizó un análisis de varianza (P ≤ 0.05), utilizando el programa estadístico SAS Versión 9.1.3 (SAS Institute, 2004), evaluando diferencias entre comunidades de bacterias en relación al tipo de tejido (UFC g-1).
Ensayo hemolítico en sangre y tinción de Gram
La prueba de hemólisis se realizó por triplicado descartando aislados bacterianos que podrían ser patógenos para los humanos siguiendo el protocolo citado por Noble (2002). Donde se consideró β-hemólisis completa como una zona clara alrededor del pocillo en el medio de agar sangre, lo que indica rotura completa de los eritrocitos, α-hemólisis parcial un color verde oscuro, indica el daño parcial de eritrocitos. Las bacterias con γ-hemólisis no presentaron alteración de color u opacidad en el medio que indique ausencia de hemólisis, de igual manera se realizó tinción de Gram de acuerdo con el protocolo del kit comercial (Golden Bell lote No. 0512227). Los aislados se separaron creando reservas las cuales fueron criopreservadas a -70 °C por triplicado, en LB líquido con 15% glicerol (v/v) según Pasarell y McGinnis (1992), para posteriores análisis.
Evaluación in vitro de promoción de crecimiento vegetal en bacterias
La evaluación de sideróforos, solubilización de fosfatos, producción de quitinasas, auxinas, IAA y actividad proteasa se realizaron de manera cualitativa, por triplicado, utilizando la cepa (B25) Bacillus cereus (Figueroa-López et al., 2016), como control positivo.
Para la producción de sideróforos, se utilizó medio agar de cromo azurol S (CAS), de acuerdo con el protocolo descrito por Schwyn y Neilands (1987); las colonias que presentaron coloración amarillo/naranja, fueron consideradas positivas. La producción de quitinasas, se realizó siguiendo la metodología descrita por Shanmugaiah, Mathivanan, Balasubramanian y Manoharan (2008), utilizando quitina como única fuente de carbono en el medio de cultivo, después de cinco días de crecimiento se observó una zona clara alrededor de la bacteria, considerándose positiva. Para evaluar la solubilización de fosfato, se utilizaron placas de agar Pikosvkaya las cuales se incubaron durante una semana a 25 oC Pikovskaya (1948), las colonias que presentaron una zona clara alrededor de la bacteria, se consideraron positivas. La producción de auxinas se evaluó cultivando las colonias en caldo LB durante 24 h y el sobrenadante fue tratado con el reactivo de Salkowsky (Loper y Schroth, 1986); según el protocolo citado por Bric, Bostock y Silverstone (1991), en la misma reacción, pasados varios minutos, se evaluó la producción de IAA identificada por cambio de color en el sobrenadante. La evaluación de la actividad proteasa se realizó en agar con leche desnatada (SMA) preparado con leche descremada comercial, según Jones, Sun y Marchesi (2007); se consideró con actividad proteasa el aclaramiento alrededor de las colonias bacterianas.
Pruebas de antagonismo in vitro
Los aislados bacterianos se enfrentaron con los siguientes fitopatógenos: Oomycete Phytophthora capsici y los hongos Sclerotium rolfsii y Colletotrichum coccodes, los cuales fueron aislados de plantas de jitomate (Solanum lycopersicum) y chile jalapeño (Capsicum annuum), la cepa del hongo Fusarium oxysporum aislado de plantas de maíz (Zea mays L.), en el estado de Sinaloa, México. Las cepas de hongos fitopatógenos fueron donados por el Centro de Investigación y Desarrollo (CIAD) en Culiacán, Sinaloa. Los hongos fitopatógenos y el Oomycete Phytophthora capsici utilizados en este trabajo se han relacionado con la pudrición de raíz en plantas de chile, jitomate, y maíz (Fernández-Herrera, Acosta, Ponce y Manuel, 2007; García-Aguirre y Martínez, 2010).
La evaluación de antagonismo in vitro se realizó en medio de cultivo papa-dextrosa-agar (PDA), con la técnica de cultivo dual (cajas de Petri, 90 × 15 mm), colocando el patógeno en el centro de la caja. En cada evaluación se realizaron tres repeticiones y se consideró utilizar tres testigos (cajas de Petri) por separado de cada uno de los fitopatógenos utilizados para este estudio. Las cajas Petri inoculadas, se incubaron por 10 días bajo condiciones controladas en cámara de crecimiento (Precision Scientific, Model 6LM, Winchester, EUA) a 28 °C. El crecimiento radial de las colonias se midió cada 24 h; al octavo día post-incubación, se midió el halo de inhibición entre las colonias en confrontación (Aquino-Martínez, Vázquez y Reyes, 2008). Para la evaluación del antagonismo se registraron las siguientes variables: crecimiento radial del antagonista (CRA), crecimiento radial del patógeno (CRP) y el porcentaje de inhibición del crecimiento radial (PICR). El PICR se determinó al sexto día de post-incubación usando la fórmula propuesta por Ezziyyani, Pérez, Sid, Requena y Candela (2004), PRGI = [(R1 - R2) / R1] × 100, donde R1 el crecimiento radial de la colonia testigo (patógeno) y R2 el crecimiento radial de la colonia del patógeno en la confrontación in vitro.
Amplificación del Gen 16S rADN y análisis filogenético
La caracterización molecular se realizó mediante la amplificación parcial del gen 16S ADNr, utilizando oligonucleótidos específicos F2C (5’-AGAGTTTGATCATGGCTC-3’) y C (5’-ACGGGCGGTGTGTAC-3’) (Shi, Reeves, Gilichinsky y Friedmann, 1997). Posteriormente se purificó el producto de PCR con el kit Wizard® _SV Gel y PCR Clean-Up System para su secuenciación, realizada en Laboratorio Nacional de Genómica para la Biodiversidad (LANGEBIO) en CINVESTAV-IPN; las secuencias obtenidas se alinearon con secuencias depositadas en el GenBank del Centro Nacional de Biotecnología de los Estados Unidos (NCBI) en el programa BLASTn (NIH, 2024). Las inferencias filogenéticas se obtuvieron con el método Neighbor Joining basado en el modelo kimura-2-parámetro con prueba bootstrap 1.000 réplicas con el programa MEGA X. (Longoria-Espinoza, Leyva, Zamudio y Félix, 2024).
Resultados y Discusión
Para el aislado de bacterias en tejido foliar, tallo y raíz de plantas de maíz se utilizaron métodos tradicionales logrando obtener once aislados, la densidad poblacional de bacterias endófitas presentó significancia en aislados de raíz (2.4 × 105 g-1), tallo (1.0 × 103 g-1) y tejido foliar (1.3 × 103 g-1), (Figura 1). Los aislados presentaron colonias traslúcidas con bordes lisos y algunas en forma de bastón y ligeramente mucosas, Gram-positivas, ocho aislados β-hemolíticos y tres γ-hemolíticos con los cuales se realizó el trabajo. Los aislados seleccionados se identificaron con base en el tejido origen (R: raíz, M: maíz), y se asignó numeración consecutiva RM1, RM2 Y RM3. Este estudio arrojó resultados similares a los reportados por Rojas et al. (2016), en plantas de maíz (Zea mays L.) híbrido P-7928, donde aislaron diez cepas de bacterias endófitas. Por otra parte, la secuenciación del producto de PCR de la amplificación parcial del gen 16S rADN permitió identificar los aislados endófitos de raíz los cuales se asociaron al phyla Firmicutes siendo el total de las cepas del género Bacillus sp., donde: RM1 (PQ187428) B. subtilis; RM2 (PQ187429) B. amyloliquefaciens y RM3 (PQ187430) B.cereus (Cuadro 1; Figura 2). Coincidiendo con otros estudios sobre diversidad de endófitos en maíz, donde las bacterias asociadas a raíz fueron Firmicutes (Bacillus), Gammaproteobacteria (Pseudomonas) (Pereira, Ibáñez, Rosenblueth, Etcheverry y Martínez, 2011) y Burkholderia spp. (Ikeda et al., 2013). Figueiredo et al. (2009), reportan mayor densidad poblacional del género Bacillus entre las bacterias endófitas en maíz tierno brasileño. Hernández, Caballero, Pazos, Ramírez y Heydrich (2003), coinciden que las bacterias más frecuentes son el género Bacillus, después de Pseudomonas, Azospirillum y Azotobacter en el cultivo de maíz (Zea mays L.) en diferentes tipos de suelos. Lo anterior nos permite relacionar que dependiendo del hospedero, tipo de suelo, tejido y ubicación geográfica se presentan modificaciones en la composición y funcionalidad de la comunidad endófita.
Cuadro 1: Identificación molecular de bacterias endófitas aisladas de tejido vegetal en plantas de maíz blanco.
Table 1: Molecular identification of endophytic bacteria isolated from plant tissue in white corn.
| Cepa | Especie/Cepa con mayor identidad en el NCBI | Pares de bases | Identidad | No. Acceso |
| (bp) | % | |||
| RM1 | Bacillus subtilis subsp. subtilis strain V783 16 S ribosomal RNA gene partial sequence | 1437 | 100 | PQ_013975.1 |
| Bacillus subtilis strain KP1116S ribosomal RNA gene, partial sequence. | 976 | 99 | PP_708111.1 | |
| RM2 | Bacillus amyloliquefaciens strain Cpl10 16S ribosomal RNA gene, partial sequence. | 1472 | 99 | MN_960274.1 |
| Bacillus amyloliquefaciens strain ZWJ 16S ribosomal RNA gene, partial sequence. | 1501 | 100 | MG_575898.1 | |
| RM3 | Bacillus cereus strain KUBOTAB5 16S ribosomal RNA gene, partial sequence. | 1512 | 99 | MK_855405.1 |
| Bacillus cereus strain AMc01NA 16S ribosomal RNA gene, partial sequence. | 1512 | 99 | MT_052656.1 |
Las bacterias promotoras de crecimiento vegetal (BPCV), son consideradas como opción sustentable, ya que se ha reportado que mediante la producción de fitohormonas, son utilizadas como agentes de control o inhibición de la colonización de fitopatógenos (Nehra, Saharan y Choudhary, 2016). Diferentes géneros se han reportado por sus diferentes características metabólicas como: Bacillus spp., Enterobacter spp., Flavobacterium spp., Azoarcus spp., Burkholderia spp., Rhizobium spp., Azotobacter spp., Chromobacterium spp., Erwinia spp., Azospirillum spp., Klebsiella spp., Micrococcous spp., Arthrobacter spp., Pantoea spp., Pseudomonas spp., Caulobacter spp., Agrobacterium spp., y Serratia spp. (Abraham-Juárez et al., 2018).
Los resultados de este trabajo, muestran a B. subtilis con capacidad de producción de hormonas y solubilización de fosfatos, considerándolo como buen candidato en promover crecimiento vegetal (Cuadro 2). B. subtilis representa gran interés como endófito, diversos estudios han demostrado que la eficiente colonización de raíces, desencadena diferentes mecanismos de biocontrol de enfermedades bióticas y abióticas (Corrales-Ramírez, Caycedo, Gómez, Ramos y Rodríguez, 2017).
Cuadro 2: Características relacionadas a promoción de crecimiento vegetal in vitro de bacterias aisladas en plantas de maíz recolectadas en terrenos del campo cuatro caminos, municipio de Guasave, Sinaloa, México.
Table 2: Characteristics related to promotion of in vitro plant growth of bacteria isolated in corn plants collected in the fields of the field Cuatro Caminos, municipality of Guasave, Sinaloa, Mexico.
| Aislado | Sideróforos | Quitinasas | Fosfatos | Auxinas | IIA | Proteasas |
| B. subtilis (RM1) | +++ | ++ | ++ | ++ | + | ++ |
| B. amyloliquefaciens (RM2) | +++ | + | +++ | +++ | ++ | ++ |
| B.cereus (RM3) | ++ | ++ | +++ | +++ | ++ | ++ |
| B Cereus **(25) | ++ | ++ | ++ | + | + | + |
Ausencia actividad (-); + ( 3mm; ++ ( 3 ( 4 mm; +++ ( 4 mm. La letra R significa raíz, M maíz, ** Control positivo. Absence of activity (-); + ( 3mm; ++ ( 3 ( 4 mm; +++ ( 4 mm. The letter R means root, M corn, ** Positive control.
Diferentes estudios de inoculación en semilla y aisladas de tejido en plantas de maíz cepas B. subtilis, demuestran que presenta capacidad de producción de hormonas, favoreciendo el incremento de absorción de nutrientes (Zhang et al., 2007). Por otra parte, los valores medios obtenidos de las variables mostradas en el Cuadro 2; coincide con lo reportado por ZeXun y Wei (2000); que prueban que cepas B. amyloliquefaciens, son productoras de fitohormonas, fijan nitrógeno y solubilizan fosfatos favoreciendo con ello el crecimiento vegetal; por otra parte diversos trabajos reportan que B. amyloliquefaciens, destaca por su actividad antagonista por lo que es utilizado como agente de biocontrol (Rodríguez-Hernández et al., 2020). Estudios del genoma de B. amyloliquefaciens, muestran un aumento significativo en metabolitos secundarios específicos como lipopéptidos relacionados con la supresión de patógenos y desarrollo de las plantas (Rodríguez-Hernández et al., 2020; Belbahri et al., 2017).
Por otra parte Bacillus cereus, aislada de tejido (raíz) mostró producción de sideroforos y alta solubilización de fosfato (Cuadro 2). Coincidiendo con Chamorro-Anaya, Chamorro y Pérez (2020), quienes aislaron B. cereus en tejido de plantas de arroz como bacteria endófita, presentando capacidad metabólica relacionada con promoción de crecimiento vegetal; incrementando la movilización de fosfato por diferentes mecanismos, aumentando la fertilidad de los suelos y estimulando el crecimiento en las plantas (Li et al., 2023; Chamorro-Anaya et al., 2020). Los resultados de la actividad antagónica experimental se muestran en la Figura 3, la inhibición del crecimiento radial del hongo osciló por arriba del 50% como se muestra en el Cuadro 3; el valor máximo de inhibición se detectó con la cepa B. subtilis (RM1) contra Sclerothium rolfsii, presentando 87.09% de inhibición. Se observó durante el ensayo de antagonismo in vitro que el crecimiento del hongo se detuvo a partir del sexto día lo que nos permite suponer que existe una alta competencia por espacio y nutrientes.
Figura 3: Antagonismo in vitro de bacterias aisladas en plantas de maíz recolectadas en terrenos del campo cuatro caminos, municipio de Guasave, Sinaloa, México. B. subtilis (RM1); B. amyloliquefaciens (RM2) y B.cereus (RM3), sobre el crecimiento micelial de Phytophthora capsici, Fusarium oxysporum y Sclerothium rolfsii.
Figure 3: In vitro antagonism of bacteria isolated in corn plants collected in fields of Cuatro Caminos, municipality of Guasave, Sinaloa, Mexico. Bacillus subtilis (RM1); B. amyloliquefaciens (RM2) and B.cereus (RM3), on the mycelial growth of Phytophthora capsici, Fusarium oxysporum and Sclerothium rolfsii.
Cuadro 3: Porcentaje de actividad antagónica de bacterias aisladas en plantas de maíz recolectadas en terrenos del campo cuatro caminos, municipio de Guasave, Sinaloa, México; frente a Oomycetes y hongos fitopatógenos.
Table 3: Percentage of antagonistic activity of bacteria isolated in corn plants collected in fields of Cuatro Caminos, municipality of Guasave, Sinaloa, Mexico; against Oomycetes and phytopathogenic fungi.
| Bacteria | Colletotrichum coccodes | Phytophthora capsici | Fusarium oxysporum | Sclerothium rolfsii |
| B. subtilis (RM1) | - | 70.13 | 67.74 | 87.09 |
| B. amyloliquefaciens (RM2) | - | 50.30 | 51.23 | 62.90 |
| B.cereus (RM3) | - | 58.24 | 69.22 | 56.32 |
El control biológico, es la principal aplicación del géneroBacillusen los agrosistemas, a su vez es utilizado para la elaboración de bioplaguicidas por su alta actividad microbiana (Chen, Tian, He, Long y Jiang, 2020). Es importante mencionar que Chamorro-Anaya et al. (2020), reportan a B. cereus en interacción positiva con la microbiota de la rizosfera, sin dejar de brindar a las plantas protección contra el ataque de patógenos. Por otra parte B. amyloliquefaciens, presenta diversos mecanismos metabólicos que favorecen su utilización como agente de biocontrol frente a diferentes patógenos como: Fusarium oxysporum f.sp. Verticillium dahliae, Erysiphe cichoracearum, Phytophthora nicotianae var. parasitica., Fusarium avenaceum f. sp. fabae, Streptomyces scabies, Setosphaeria turcica, Monilinia fructigena, Alternaria alternata, F. graminearum, Gaeumannomyces graminis, lycoperisci, Botrytis cinerea y F. solani (Castro-del Ángel, Hernández, Gallegos y Ochoa, 2021; Jiao et al., 2020). Se han reportado diversas especies endofíticas de Bacillus aisladas en plantas de maíz, como productores de lipopéptidos antifúngicos y antimicrobianos que actúan como mecanismo de inductor a la respuesta de defensa ante el ataque de patógenos. (Rodríguez-Hernández et al., 2020).
Conclusiones
Es de suma importancia considerar que la abundancia de las bacterias aisladas podría asociarse a varios factores como: condiciones climatológicas, calidad y tipo de suelo, fenología de la planta de maíz, ciclo de cultivo así como las características genéticas de la bacteria, factores que son considerados importantes en la colonización y dinámica de las comunidades de bacterias endófitas. Los resultados obtenidos en este trabajo permitieron identificar a Bacillus subtilis, B. amyloliquefaciens y B. cereus, en raíz de plantas de maíz las cuales mostraron capacidad de promoción de crecimiento vegetal así como actividad antagonista contra hongos fitopatógenos. En la actualidad son pocos los reportes de especies de Bacillus aisladas de plantas de maíz blanco, cultivado en el municipio de Guasave, Sinaloa, México. Por lo anterior, podemos concluir que las bacterias endófitas establecen una interacción positiva, desempeñando un papel importante para el desarrollo de futuras estrategias biotecnológicas en la producción de maíz blanco, como una potencial alternativa de agricultura sostenible, que tanto requiere el campo sinaloense.
Contribución de los Autores
Conceptualización: R.M.L.E. Metodología: R.M.L.E. y G.M.Z.A. Software: R.F.G. y R.M.L.E. Validación: R.M.L.E. y R.F.G. Análisis formal: R.M.L.E. Investigación: R.M.L.E. y R.F.G. Recursos: R.M.L.E. Curación de datos: R.M.L.E. y R.F.G. Escritura, preparación de borrador original: R.M.L.E. Escritura, revisión y edición: R.M.L.E. y R.F.G. Visualización: R.M.L.E. y R.F.G. Supervisión: R.M.L.E. Administración del proyecto: R.M.L.E. Adquisición de fondos: R.M.L.E.

















